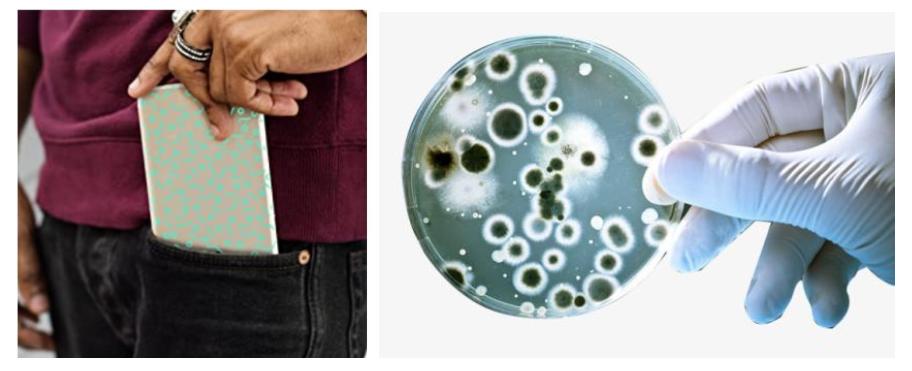
被忽略的王者英雄,被忽视的王者英雄

最近,洗手应该又成为很多人一天中做得最多的一件事,每洗一次手,就仿佛自己的安全系数在自动+1。

不仅如此,免洗消毒液、酒精湿巾更是随身携带。我们的公共卫生习惯越来越好,但,其实,有一个被忽略了的消毒细节,隐藏并威胁着我们的健康。
我们的手会不断接触电脑、手机、钥匙、证件和衣物。其实这些物品也会通过我们的手,成为新的污染源。
你看不到的地方可能是细菌和病毒的培养皿
在一项对手术室工作人员的手机检测中,96.36%的手机都检测出了不同的细菌,更有67.27%的手机细菌超标。
而针对这些,使用频率高,微生物聚集的物体的表面消毒,有一个消毒的利器,似乎一直被大家忽略,那就是UVC-LED消毒器。
一、为什么说UVC-LED是终极消毒器?
1.我们常说的太阳光紫外线就是杀菌光线吗?不是!
很多人认为阳光就是良好的杀菌光线。其实不然,大气层阳光的光谱比较杂:有红外光、可见光和少量紫外线。
其中,紫外线的波长范围在100-400nm之间,可分为UVA(长波紫外,315-400 nm)、UVB(中波紫外,280-315 nm)、UVC(短波紫外,200-280nm)和VUV(100-200nm)。大气内阳光中的紫外线以UVA为主(90%),有极少的UVB(大部分被臭氧层吸收,低于10%),UVC及以下,穿透性极差,被臭氧层和大气吸收殆尽。而我们肉眼可见的波长范围为380-780nm之间,所以我们大部分人只能看到紫外线中的UVA部分。

光谱的波长分布
紫外线中,UVA的光子能量最低,穿透性最强,可以穿透大部分玻璃以及塑料,也可以穿透我们皮肤的表皮层,直达真皮层,破坏弹性纤维和胶原蛋白纤维,将皮肤晒黑。
UVA经常被用于油墨固化、验钞和植物生长等领域,也有用于捕蚊灯和美甲灯的,不能直接杀菌除螨。
UVB的穿透能力居次,波长较短的部分会被透明玻璃吸收,对人体具有红斑效应,可以用于白癜风、皮肤慢性溃疡、特应性皮炎等皮肤疾病,大剂量辐照可致癌。
UVC的穿透能力最差,无法穿透大部分的透明玻璃及塑料,也不能穿透皮肤的表皮层,具有极强的杀菌消毒功能,也被称为灭菌紫外线,被广泛应用于医疗消毒场景。
UVC是波长最短能量最高的一个波段,实际上对于杀菌消毒,真正最有效的就是UVC这个被称为深紫外的波段。
UVC的高能量光子容易被生物体的核酸分子直接吸收,从而直接破坏及改变微生物的DNA或RNA的分子结构,使微生物当即死亡或无法繁殖。

UVC直接破坏DNA分子结构
但是,在用于消毒时,应当做好皮肤和眼睛防护。大剂量的UVC长时间照射皮肤,会导致脱皮,对裸眼的危害极大。
2. UVC-LED是我们常说的紫外线杀菌灯吗?不一定!
我们通常使用的紫外线杀菌灯,是利用UVC的灭菌效应,通常用石英玻璃制成低压汞灯,使用寿命为几百小时。

正在杀毒的紫外汞灯
实际上,汞灯紫外线只是紫外线消毒的方式之一,且它还有一个很棘手的缺陷,那就是汞具有很强的毒性,一旦汞灯破裂,汞蒸气被人体吸入,就会造成不可逆转的伤害。
除此以外,汞灯紫外线还会产生臭氧,伤害人体的呼吸道黏膜,所以其设备一般适用在比较大型的无人场所。
上世纪90年代,美国南卡罗来纳大学的著名半导体物理学家Asif Khan制备出第三代氮化物半导体材料的AlGaN/GaN多量子阱结构,并产生电致发光效应,辐射出微弱的UVC光线。他们小组在NASA的资助下,发明了UVC-LED,并将该成果最早用于航天的消毒应用中。

后来,他们基于该项成果,成立了世界上第一家制造UVC-LED的高科技企业,最早推出的UVC-LED的价格比同等重量的黄金贵1000多倍!
值得一提的是,Asif Khan小组和他所创办的SETi公司(现已被韩国首尔半导体收购)里最杰出的工程师之一是原中科院半导体研究所的博士,华人科学家张剑平先生。
UVC-LED全称为C-band ultraviolet light emitting diode,顾名思义,是能辐射出UVC的发光二极管,跟可见光的发光二极管一样,是一种半导体发光器件,固态冷光源,由直流驱动。
不仅如此,能发射出LED紫外线的消毒灯珠体积很小,适合做成很多便携设备,能够在外出旅游等随身携带,这是很多传统消毒方式所不具备的。

LED灯珠

市面上UVC-LED集成的杀菌水杯、消杀手电、消杀盒子产品
二、UVC-LED为什么可以“秒杀”病菌?
其实,人体体重的1/3左右都是微生物(包括细菌、真菌、病毒等),有些对人体有危害,有些则对人体有益。经过长期演化和适应,一个健康的人与其所携带的微生物保持在一种动态的平衡之下。
但是当一个人类原有环境中未曾出现过的微生物种群出现,很可能会打破这种平衡,击溃人类的免疫系统,导致患病甚至致死。而隔离人和这类微生物,最有效的手段就是对表面、空气、水和食物等进行消毒,直接消除传染源的威胁。
1、 生活中的几种消毒方式
现代消毒方法有很多,其中消毒剂是大家常用的一种手段,但是日常所用的消毒剂,有些并不能用在这些物品上使用,比如次氯酸钠、双氧水,这些化学消毒灭菌的方式,效能很高,但是具有很强的腐蚀性,不易用在手机、电脑等表面。

酒精也是居家外出很多人喜欢使用的消毒剂,但是需要注意的是,酒精也是一种易燃液体,而且非常的易挥发,不能长时间停留在物体表面,除非是浸泡式的消毒,否则效果并不明显。
目前,消毒灭菌高效、广谱的是辐射杀菌法,包括有紫外线照射法和电离辐射法,通常用同位素Co-60作为伽马射线源。这些射线被称为微生物的“核*器武**”。
但由于放射线对人体的毒害,在使用的时候需要特别防护。
紫外线消毒,利用高能紫外线使得分子发生化学反应,细菌、病毒的蛋白质和核酸都因此而被破坏,是一种简单高效的消毒方式。
此外,在居家环境里,很多人喜欢用高温蒸煮来消毒,这样的方式可行,但是却并不很可取。
有研究表明,高温消毒要真正达到预期效果必须同时具备两个条件:一个温度,另一个是时间。一般来说,100℃沸水,持续5分钟以上,才可以杀死或灭活一部分细菌和微生物。外出就餐“开水烫碗“也只能杀掉3%的细菌。
2、 UVC-LED的高灭菌效率

自从波长集中、小型化、易集成、便于控制的UVC-LED新型紫外线光源发明以来,为紫外线消毒的打开方式提供了另一种可能。
传统的UVC光源是汞灯,毒害性极大,《关于汞的水俣公约》也自2017年8月16日起在中国生效。该公约要求从2021年1月1日起,禁止生产和进出口规定的含汞产品,汞灯,也包含在内。所以,今年开始要全面禁汞了。此外,这种光源虽然便宜,而且功率大,但是我们知道,其UVC的成分不高,需要高电压才能激发出不到20%的UVC组分,而且其他波段的光还有可能起到对微生物的活化作用。
还有一个更关键的问题,就是含UVC成分高的汞灯,其体积大,不好安置,UVC光容易被各种东西遮挡或者吸收。用它来大面积消毒尚可,但是小角落就无能为力了。
UVC-LED的妙处在于体积小,能摆脱空间束缚,波长集中,小功率(1mW)的UVC-LED就能达到几十瓦汞灯辐射出的UVC强度。

消杀手电产品
国标GB/T 19258-2012《紫外线杀菌灯》要求4W标称功率的双端灯在1 米处的辐照度达到11uW/cm²;36W双端灯1米处的辐照度为135uW/cm²。而4颗UVC-LED在距离5cm处,就可以达到400uW/cm²,照射30秒,即可达到非常好的灭菌效率。
三、被低估的UVC-LED,有什么前景和局限?
由于UVC-LED的造价成本高,目前依然是汞灯管的几百倍(元/瓦),但是从安全性、体积小、易于集成和控制上看,UVC-LED远远被行业和用户低估了,甚至遭到了很多人的无视。
因为,人们在居家和教室内使用汞灯长时间消毒时,经常误入消毒空间内,导致皮肤和眼睛灼伤的事故频频发生。但是之后市场上多于劝阻使用紫外灯,却没有对传统紫外灯和UVC-LED作区分。
除了灭菌作用,其实UVC-LED还有很多用途。比如,高性能的固化光源,可用于3D打印上,因为光子能量高,对几乎所有规格的薄层固化剂可以进行固化,也可以用于地下或卫星探矿,以及用于保密性极高的紫外光通信等。
当然,由于这种光源芯片的制备工艺比较复杂,技术难题还有很多,芯片的效率和功率水平还偏低。但是这些都是阶段性的困难,一旦技术瓶颈突破,UVC-LED将会为我们打开一个新的探索世界、探索宇宙的方式。
而一种新的科学的消毒方式,也终将成为一种习惯被人类传承。